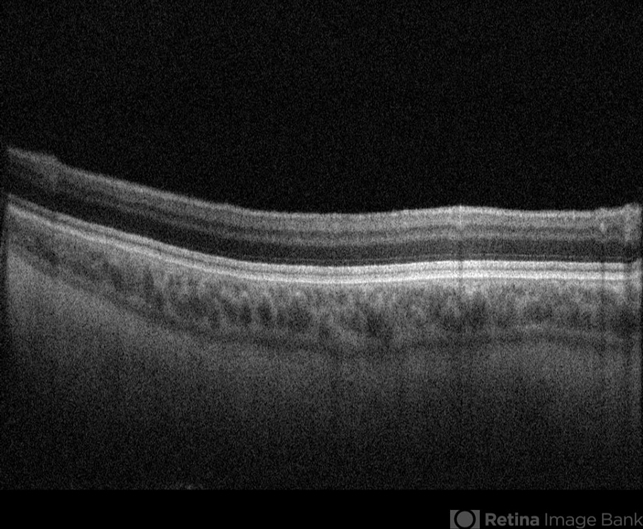

-
 By Dr.Anushri Godbole
By Dr.Anushri Godbole
Isha netralaya
Co-author(s): Dr.Amit Nene, Dr.Sheetal Divate, - Uploaded on Aug 18, 2023.
- Last modified by Joshua Friedman on Aug 21, 2023.
- Rating
- Appears in
- Miscellaneous
- Condition/keywords
- ocular albinism
- Imaging device
- Optical coherence tomography system
- Description
- 41 years old male came to opd with chief complaints of diminution of vision of both eyes since childhood. BCVA RE- FC 2M, LE- 6/60. On examination, patient had BE nystagmus. Fundus was tessellated with prominent choroidal blood vessels and Foveolar hypoplasia. Diagnosis of BE ocular albinism was made..

Initializing download.
Initializing download.










